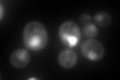
YER095W
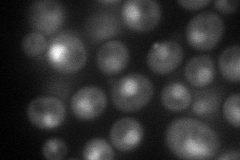
YER095W
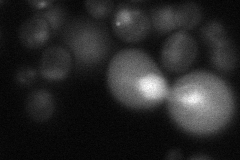
YER095W
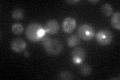
YER095W

View description
Strand exchange protein, forms a helical filament with DNA that searches for homology; involved in the recombinational repair of double-strand breaks in DNA during vegetative growth and meiosis; homolog of Dmc1p and bacterial RecA protein
Localization:
Intensity:
Fold change:
Significance:
-
C’ GFP library in SD
nucleus, punctate87.88 -
N' NOP1pr-GFP in SD
cytosol73.8022 -
N' TEF2pr-mCherry in SD

cytosol,nucleus13.3354 -
N' NATIVEpr-GFP in SD
nucleus35.4727 -
N' TEF2pr-VC and Cyto-VN in SD

punctate,nucleus55.3692 -
C’ GFP library in SD+DTT

nucleus, punctateN/AN/ANo -
C’ GFP library in SD+H2O2

nucleus, punctate83.450.94No -
C’ GFP library in Starvation Media
nucleus, punctate89.891.02No -
C’ GFP library on the background of Pup2-DaMP

nucleus, punctate -
C’ GFP library on the background of CCT mutant

nucleus, punctate48.80340.555268Yes
